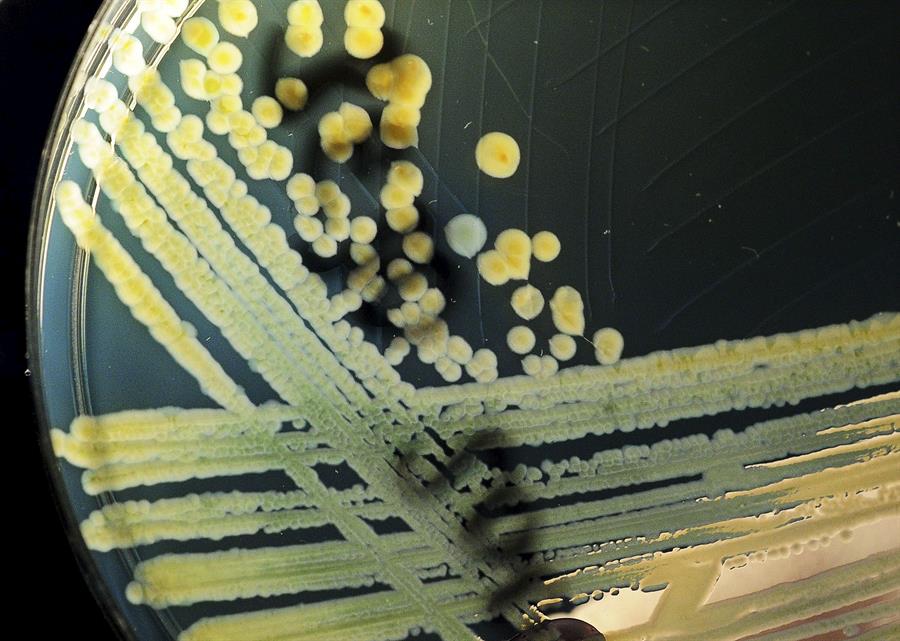

Ginebra, 11 feb (EFE).- Científicos apoyados por el Fondo Nacional Suizo (FNS) confirmaron hoy que algunas bacterias se vuelven inactivas o “se ponen en guardia” para sobrevivir a los antibióticos y que una vez terminado el tratamiento recuperan su virulencia, lo que las hace muy difíciles de tratar.
Los científicos demostraron que estas bacterias ralentizan su metabolismo, pero no realizan una parada completa, sino que se quedan en “estado de vigilia” para sobrevivir mejor a un entorno hostil, informó el FNS mediante un comunicado.
La comprensión de esta estrategia de supervivencia constituye un avance importante para la medicina porque puede ayudar a desarrollar nuevos tratamientos contra las bacterias que adoptan este comportamiento.
“Creemos que si logramos reactivar el crecimiento de estas bacterias, los antibióticos podrán eliminarlas», explicó la profesora de Infectología del hospital cantonal de Zúrich y una de las autoras del estudio, Annelies Zinkernagel.
Los científicos del equipo de Zinkernagel demostraron que los derivados de la vitamina A, que se dirigen a la membrana celular, son prometedores para eliminar las bacterias cuyo metabolismo se ralentiza.
«La existencia de bacterias con metabolismo lento no es completamente nueva. Sin embargo, todavía no había unanimidad entre los científicos», explicó Zinkernagel, quien aseguró que su estudio ahora lo confirma con una “alta precisión”.
El problema más conocido en este ámbito es el de las bacterias resistentes, que consiguen volverse insensibles a los antibióticos, pero este estudio demuestra que las bacterias no resistentes también tienen estrategias efectivas para sobrevivir, por lo que los antibióticos tampoco funcionan siempre contra ellas.
Estos hallazgos son importantes en la lucha contra la resistencia a los antibióticos, que aumenta en las infecciones recurrentes que requieren tratamientos largos.
Es justamente una prolongada exposición de estos patógenos a los antibióticos lo que aumenta el riesgo de que sobrevivan.
Curadas / Vía Agencia EFE
La mayoría de los microorganismos patógenos tienen esa estrategia, así como lo hacen las bacterias, lo hacen los virus que se van atrincherar en las articulaciones dónde lograr inactivarse mientras la acción del antibiótico disminuye su efectividad, los hongos también sus esporas se alejan de los antimicóticos, los parásitos suelen morir los pequeños y otros se alejan del poder de los antiparasitarios, los protozoarios se enquistan protegiéndose del los químicos pero si utilizamos el DIÓXIDO DE CLORO en dosis adecuadas ningún patógeno podrá resistir la acción del gas ClO2 (dióxido de cloro) el cual les rompe su pared celular cubierta de proteína, les intercambia los electrónes por el ión de cloro y automáticamente hay desprendimiento de energía produciendo al patógeno una oxidación a sus células, una apoptósis, el patógeno básicamente es oxidado por la molécula de ClO2, haciendo muy efectivo el ataque dentro del cuerpo humano. La acción es rápida y los patógenos se sienten sorpresivamente destruidos sin poder desarrollar resistencia a la molécula del dióxido de cloro, además se recomienda tomar todos los días, todo el año en dosis bajas para prevenir de otras enfernedades, NO ES TOXICO Y NO CAUSA EFECTOS SECUNDARIOS, este año cumpliré 10 años tomando todos los días la mínima dosis y como resultado en todo ese tiempo ningún microorganismos patógeno ha infectado mi cuerpo.
Pero no informan cuales son esas «tramposas.»